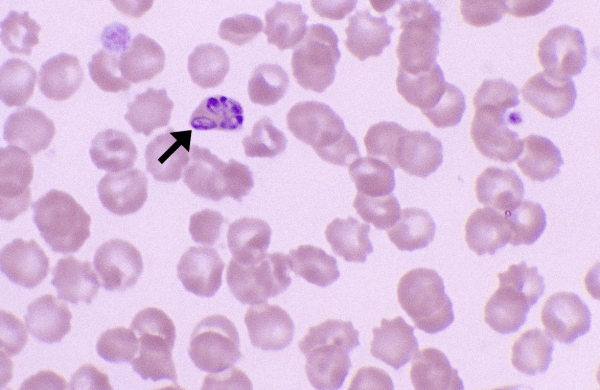

Babesia
Morphology: single or multiple pear-shaped (pyriform) organisms within red blood cells. Organisms stain dark purple around the periphery and clear in the centre. Look alike: Histoplasma capsulatum Commonly seen with: other tick-borne rickettsial… Read more Babesia →
